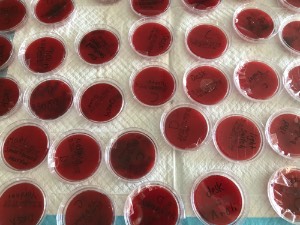

The Worm Project

The Worm Project was a collaborative program between Stony Brook University faculty
and Riverhead Central School District. The program introduced an elementary age,
English learner to STEM in a fun interactive manner. The primary goal of the Worm
Laboratory Summer Program at Riverhead Central School District was to offer elementary
school students an opportunity to observe science phenomena and design experiments
to explain what they have observed. 
This falls in line with the Next Generation Science Standards (NGSS) goals which have
recently been conceptualized by the National Research Council. School Districts across
Long Island are challenged with incorporating these new concepts into the elementary
curriculum. Additionally, the introduction of the New York State Assessments in ELA
and Math six years ago has greatly reduced the amount of time elementary school teachers
spend on science since the students now begin taking these assessments in third grade.
During the Worm Laboratory Summer Program students received three weeks of instruction
in key age appropriate disciplinary core areas of science, connect concepts and new
learning to prior knowledge, and learned skills to investigate and design systems
to test scientific problems.
 Another goal is to expose Stony Brook Undergraduate students to experiential learning
activities where they are learning and helping others at the same time. This was accomplished
by having SBU Undergraduate students attending the program to assist the primary instructors.
The primary instructors were Jeannie Guglielmo, Clinical Associate Professor from
the Clinical Laboratory Sciences Department and Mr. Erik Flynn, Clinical Lecturer,
both from the School of Health Technology and Management. Students were recruited
by collaborators to include Clinical Assistant Donna Crapanzano from the BSHS major,
Carrie-Ann Miller from the National Center for Science and Civic Engineering and the
Director of Experiential Learning Programs for STEM Smart Programs, and Dr. Sharon
Pochron, Faculty Director: Ecosystems and Human Impact, Sustainability Studies, and
Earthworm Ecotoxicology Lab Director.
Another goal is to expose Stony Brook Undergraduate students to experiential learning
activities where they are learning and helping others at the same time. This was accomplished
by having SBU Undergraduate students attending the program to assist the primary instructors.
The primary instructors were Jeannie Guglielmo, Clinical Associate Professor from
the Clinical Laboratory Sciences Department and Mr. Erik Flynn, Clinical Lecturer,
both from the School of Health Technology and Management. Students were recruited
by collaborators to include Clinical Assistant Donna Crapanzano from the BSHS major,
Carrie-Ann Miller from the National Center for Science and Civic Engineering and the
Director of Experiential Learning Programs for STEM Smart Programs, and Dr. Sharon
Pochron, Faculty Director: Ecosystems and Human Impact, Sustainability Studies, and
Earthworm Ecotoxicology Lab Director.
The implementation plan involved delivering a three-week summer program. Each day
had a similar schedule. There were three blocks of instruction, each 45 minutes in
duration. Block one included introduction activities, a demo or video, and discussion of what
students know, want to know, and ultimately learned (KWL). The second block of time
was designated for hands-on activity related to the worm laboratory design and set-up.
Block one included introduction activities, a demo or video, and discussion of what
students know, want to know, and ultimately learned (KWL). The second block of time
was designated for hands-on activity related to the worm laboratory design and set-up.
Block number three included activities reinforcing the information learned during
the first two blocks, crosscutting concepts to connect with other subject areas such
as ELA, math, history and civic issues.

A successful summer with future
STEM students!
